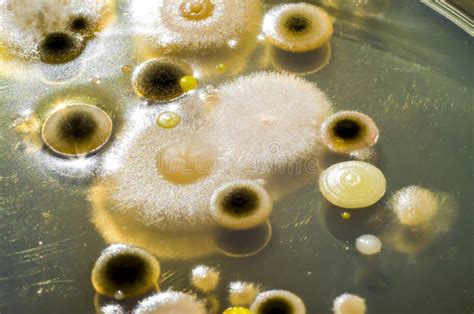
Microscopio con mostra di batteri e funghi

La storia di Catena Zapata è una saga familiare che affonda le sue radici nel lontano 1902, quando Nicola Catena, un immigrato italiano proveniente dalla regione delle Marche, piantò il suo primo vigneto a Mendoza, Argentina. Da allora, la cantina è rimasta saldamente nelle mani della famiglia, giungendo oggi alla quarta generazione, incarnata dalla Dottoressa Laura Catena. Questa eredità, unita a un approccio scientifico all'avanguardia, ha permesso a Catena Zapata non solo di preservare la ricca tradizione vinicola argentina, ma anche di elevare il Malbec a un livello di riconoscimento globale, posizionando l'Argentina sulla mappa mondiale del vino di qualità.

La Visione Scientifica di Laura Catena: Oltre la Tradizione
Laura Catena, una figura poliedrica che unisce le competenze di biologa, medico specializzato in pronto soccorso e autrice acclamata, guida Catena Zapata con una filosofia che fonde scienza, cura e tradizione. La sua formazione medica, maturata tra Harvard e Stanford, ha plasmato un approccio unico alla viticoltura, focalizzato sulla longevità e sulla salute delle viti, in particolare delle vecchie vigne. "Se puoi salvare una persona, perché non salvare anche una pianta?" riflette, evidenziando la profonda connessione tra la cura della vita umana e quella vegetale.
Fondato nel 1995, il Catena Institute of Wine è il fulcro di questa visione scientifica. Qui, il team di Laura si dedica allo studio della longevità della vite, della sua resilienza e degli ecosistemi microbici che ne garantiscono la salute. "Le vecchie vigne sono più forti di quelle giovani," spiega Laura. "Sono più resilienti, con radici più profonde e un equilibrio migliore." Questa enfasi sulla longevità è ulteriormente rafforzata dalla presenza di numerosi vigneti storici di Catena Zapata non innestati, una rarità nella viticoltura moderna. La ricerca del team ha dimostrato che le vigne non innestate tendono a vivere più a lungo di quelle innestate, grazie a una simbiosi ottimale tra le radici e il terreno. "Abbiamo vigneti geneticamente diversi, selezioni massale, ogni vite leggermente diversa dalla successiva," afferma Laura, sottolineando la diversità genetica come un pilastro della resilienza.
Il Catena Institute of Wine utilizza la scienza non per alterare la natura, ma per preservarla. Questa filosofia si estende all'ecosistema più ampio del vigneto, includendo i microbi. La ricerca di Laura sul microbioma del vigneto ha svelato un mondo sotterraneo vibrante, dove batteri e funghi collaborano per sostenere la salute della vite. "Alcuni rizobatteri rendono le viti più felici, producono più foglie, più fotosintesi," spiega. "È proprio come la salute umana. I microbi non sono nemici; sono essenziali."
L'Eredità Familiare e la Rivoluzione del Malbec
La storia di Catena Zapata è indissolubilmente legata alla visione di Nicolás Catena Zapata, padre di Laura, che negli anni '80 intraprese una vera e propria rivoluzione nel panorama vinicolo argentino. Il suo sogno era ambizioso: porre l'Argentina sulla mappa mondiale del vino di qualità, competendo con le grandi denominazioni europee. Inizialmente scettica, Laura fu presto travolta dalla passione paterna e dalla possibilità di contribuire a realizzare questa visione.
"Mio padre aveva questo sogno: mettere l'Argentina sulla mappa mondiale del vino di qualità," racconta Laura. "Pensavo che sarebbe fallito, perché la concorrenza era troppo forte." La sua decisione di dedicarsi a tempo pieno all'azienda, lasciando la pratica medica nel 2019, segnò un punto di svolta, consolidando la sua leadership sia come Direttrice Generale sia come mente scientifica dell'azienda.
Catena Zapata è oggi universalmente riconosciuta per i suoi Malbec, che costituiscono circa il 46% della loro produzione. La linea "Catena Zapata" rappresenta il vertice qualitativo dell'azienda, con vini di singolo vigneto provenienti da parcelle d'eccellenza come Nicasia e Arianna. Questi vini, in particolare l'annata 2013 che ha raggiunto prezzi di circa 1.300 euro, sono considerati dei veri e propri miti, detentori del titolo di vino più costoso dell'Argentina e garantiti per resistere alla prova del tempo. Anche il Malbec Argentino, a una fascia di prezzo più accessibile (circa 80 euro a bottiglia), merita un'attenzione particolare.
Por qué Argentina es campeona del Malbec y qué tuvo que ver Sarmiento │ #BIZELANEAS 33
Vigneti d'Alta Quota e il Concetto di Longevità
I vigneti d'alta quota di Catena Zapata, alcuni situati a oltre 1.400 metri sul livello del mare, sono testimonianze viventi di resilienza e adattamento. In queste condizioni estreme, il concetto di longevità assume un significato ancora più profondo. Le escursioni termiche marcate tra il giorno e la notte, l'intensa radiazione solare e i terreni poveri ma ben drenati contribuiscono a creare uve di eccezionale concentrazione e complessità aromatica.
Questi terroir unici permettono alle viti, in particolare a quelle più vecchie, di sviluppare sistemi radicali profondi capaci di attingere a risorse idriche e nutrienti essenziali. La diversità genetica dei cloni di Malbec preservati da Catena Zapata, insieme alla pratica di lasciare molte vigne non innestate, favorisce una maggiore capacità di adattamento alle sfide ambientali, conferendo ai vini una distintiva eleganza e un potenziale di invecchiamento prolungato.
Sostenibilità e Comunità: Un Ecosistema Integrato
La filosofia di Laura Catena si estende oltre la cura delle viti, abbracciando anche il benessere delle persone che dedicano la loro vita alla coltivazione dei vigneti. Catena Zapata si impegna attivamente nella creazione di una comunità prospera attorno ai suoi vigneti, offrendo oltre 180 abitazioni per il personale e le loro famiglie, incoraggiandoli a coltivare il proprio cibo e ad allevare animali. "È una comunità," afferma Laura. "L'ecosistema di una vite include persone, microbi e animali vicini."
Questo approccio olistico alla sostenibilità è integrato in ogni aspetto delle operazioni di Catena Zapata. L'azienda contribuisce attivamente al Codice di Sostenibilità argentino, collaborando con le principali università internazionali per promuovere pratiche agricole rispettose dell'ambiente e socialmente responsabili.
Leadership Femminile e Ispirazione per le Nuove Generazioni
Laura Catena, oltre a essere una figura di spicco nel mondo del vino, è un modello di leadership per le donne in settori tradizionalmente dominati dagli uomini, come la viticoltura e la scienza. La sua esperienza come madre di tre figli, che ha bilanciato con una carriera intensa, le ha fornito una prospettiva unica sulla cura e sulla leadership. "Essere madre, o semplicemente avere cura, si applica a tutto: le viti, le persone con cui lavoro, amici e famiglia," riflette.
Il suo consiglio per le giovani donne che intraprendono percorsi simili è pragmatico e ispiratore: "Prima di tutto, trova qualcosa che ami fare. Non puoi eccellere in qualcosa che non ami. Ogni lavoro ha parti spiacevoli, quindi quando trovi la tua passione, non lasciare che i giorni difficili ti fermino. E studia, studia davvero. Vai a conferenze, leggi articoli scientifici. Non affidarti solo ai riassunti o a quello che ti dice l'intelligenza artificiale."

Innovazione nella Comunicazione e nel Marketing
Catena Zapata ha saputo coniugare la sua ricca eredità con strategie di comunicazione innovative per raggiungere un pubblico globale e creare una community appassionata di vino. I social media sono diventati uno strumento cruciale per celebrare le vittorie e condividere la storia dell'azienda. Inoltre, l'inserimento della storia del Malbec sulle etichette delle bottiglie ha rappresentato un modo efficace per aumentare la conoscenza di questa varietà in tutto il mondo.
La capacità di differenziarsi attraverso l'autenticità è un altro pilastro del successo di Catena Zapata. Come sottolineato da Nicolás Catena, mantenere la leadership richiede non solo eccellenza, ma anche la volontà di fare qualcosa di diverso. L'azienda incoraggia un ambiente in cui il criticismo costruttivo è visto come un'opportunità di miglioramento, portando a risultati significativi e a un perfezionamento continuo delle proprie iniziative.
Alejandro Vigil: Un Altro Pilastro dell'Eccellenza Enologica Argentina
Sebbene Laura Catena sia la figura centrale della guida scientifica e strategica di Catena Zapata, l'enologo Alejandro Vigil gioca un ruolo fondamentale nel successo della cantina. Riconosciuto come "uomo dell'anno" da Decanter Magazine nel 2009, Vigil è una figura carismatica e un vero e proprio pilastro dell'enologia argentina.
Oltre a supervisionare la produzione di Catena Zapata, Vigil è noto per il suo progetto personale, El Enemigo, che ha contribuito a elevare la reputazione di vitigni come la Cabernet Franc e la Bonarda in Argentina. La sua versatilità si estende anche alla gestione di ristoranti e cervecerie a Mendoza, dimostrando una passione e una visione imprenditoriale a tutto tondo. La sua collaborazione con Adrianna Catena, sorella di Laura, in iniziative come El Reventón a Gredos, Spagna, sottolinea ulteriormente il profondo legame tra la famiglia Catena e l'innovazione nel mondo del vino. L'interesse di Vigil per la Garnacha spagnola, con la sua capacità di esprimere il terroir pur mantenendo una forte identità varietale, riflette una ricerca continua di espressioni enologiche uniche e di alta qualità, comparabili ai grandi vini della Borgogna.
La continua dedizione di Catena Zapata alla ricerca scientifica, alla preservazione delle vigne antiche e alla costruzione di una comunità forte, guidata dalla visione di Laura Catena e supportata da talenti come Alejandro Vigil, assicura che il nome Catena Zapata continuerà a risplendere nel firmamento del vino mondiale per le generazioni a venire.